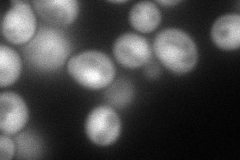
YER174C
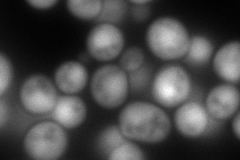
YER174C

View description
Hydroperoxide and superoxide-radical responsive glutathione-dependent oxidoreductase; monothiol glutaredoxin subfamily member along with Grx3p and Grx5p; protects cells from oxidative damage
Localization:
Intensity:
Fold change:
Significance:
-
C’ GFP library in SD

below threshold16.36 -
N' NOP1pr-GFP in SD
cytosol,nucleus124.357 -
N' TEF2pr-mCherry in SD
nucleus231.91 -
N' NATIVEpr-GFP in SD

cytosol37.892 -
N' TEF2pr-VC and Cyto-VN in SD

cytosol56.9485 -
C’ GFP library in SD+DTT

cytosol17.21.05No -
C’ GFP library in SD+H2O2

cytosol13.220.8No -
C’ GFP library in Starvation Media

cytosol17.491.06No -
C’ GFP library on the background of Pup2-DaMP

below threshold -
C’ GFP library on the background of CCT mutant

below threshold17.51221.07008No
